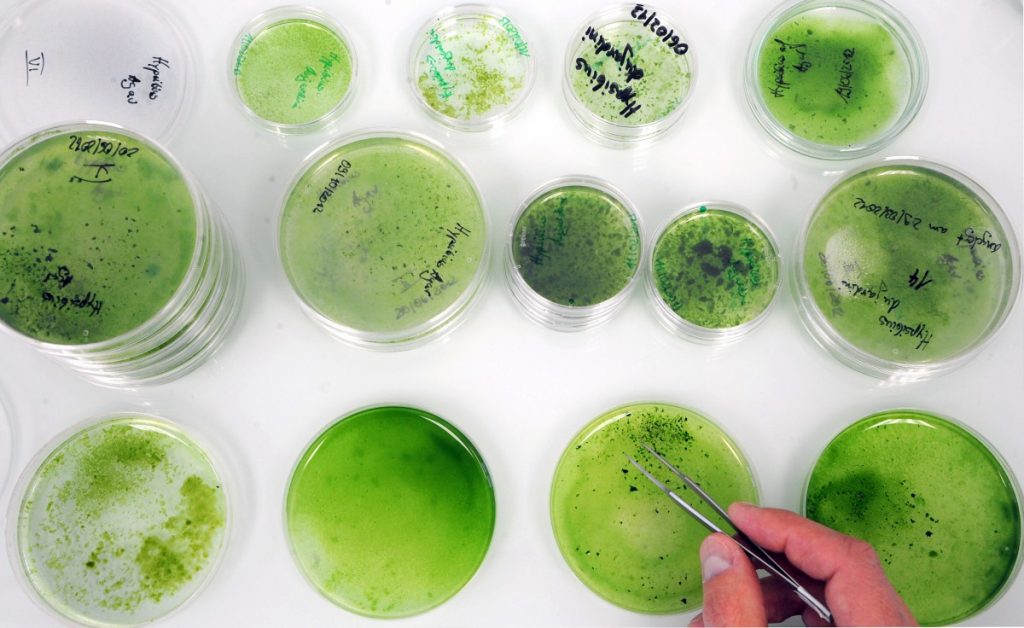

Japanische Forscher haben das Geheimnis gelüftet, welches es manchen Kleinstlebewesen ermöglicht, trotz der extremen radioaktiven Strahlung im Weltraum zu überleben. Möglicherweise lässt sich das Prinzip auch auf größere Lebewesen übertragen.
Bärtierchen sind die größten bekannten Überlebenskünstler. Man kann sie kochen, einfrieren, zerquetschen, austrocknen oder ins Weltall schießen – die nur einen Millimeter kleinen Achtbeiner überleben all diese Qualen. Offenbar sogar weitgehend unbeschadet.
Als Forscher vor knapp zehn Jahren erstmals ein paar Tausend dieser winzigen Wassertierchen per Satellit ins Weltall schickten, hatten sie sich bis zu ihrer Rückkehr zur Erde ein paar Wochen später sogar erfolgreich vermehrt – trotz des Vakuums und einer für so ziemlich alle anderen Lebewesen tödlichen Strahlendosis. Zur größten Überraschung der Forscher waren die im All gezeugten Jungtiere vollkommen gesund. Lange konnten sich die Forscher nicht erklären, wie die Tiere es geschafft haben, ihr Erbgut vor Strahlenschäden zu schützen. Jetzt haben Forscher der Universität Tokio das Geheimnis der Bärtierchen gelüftet.
Als Forscher vor knapp zehn Jahren erstmals ein paar Tausend dieser winzigen Wassertierchen per Satellit ins Weltall schickten, hatten sie sich bis zu ihrer Rückkehr zur Erde ein paar Wochen später sogar erfolgreich vermehrt – trotz des Vakuums und einer für so ziemlich alle anderen Lebewesen tödlichen Strahlendosis. Zur größten Überraschung der Forscher waren die im All gezeugten Jungtiere vollkommen gesund. Lange konnten sich die Forscher nicht erklären, wie die Tiere es geschafft haben, ihr Erbgut vor Strahlenschäden zu schützen. Jetzt haben Forscher der Universität Tokio das Geheimnis der Bärtierchen gelüftet.
Erbinformation wird geschützt
 Bei der Analyse des Bärtierchengenoms stieß das Team von Professor Takekazu Kunieda auf ein Gen, welches für die Herstellung eines einzigartigen Proteins verantwortlich ist. Dieses Protein legt sich offenbar wie ein Kokon um die DNA und schützt die Erbinformationen vor schädlichen Umwelteinflüssen, ohne sie dabei in ihren normalen Funktionen zu behindern.
Bei der Analyse des Bärtierchengenoms stieß das Team von Professor Takekazu Kunieda auf ein Gen, welches für die Herstellung eines einzigartigen Proteins verantwortlich ist. Dieses Protein legt sich offenbar wie ein Kokon um die DNA und schützt die Erbinformationen vor schädlichen Umwelteinflüssen, ohne sie dabei in ihren normalen Funktionen zu behindern.
Wie dieser Schutzmechanismus im Detail funktioniert, haben Kunieda und seine Kollegen noch nicht erforscht. Doch sie haben nachgewiesen, dass dieses proteinproduzierende Gen maßgeblich für den Strahlenschutz verantwortlich ist.
Menschliche Zellen zeigen höhere Strahlentoleranz
 Die Forscher haben das Gen in menschliche Nierenzellen transferiert, damit auch diese das Bärtierchenprotein produzieren. Als Kunieda diese Zellkulturen dann extremer Röntgenstrahlung aussetzte, zeigten sie 40 Prozent weniger Schäden als unbehandelte menschliche Zellen. „Da dieses Gen die Strahlentoleranz in menschlichen Zellkulturen extrem verbessert hat, hoffe ich, dass wir es irgendwann schaffen werden, die Strahlentoleranz größerer Lebewesen zu verbessern“, sagte Kunieda bei der Vorstellung seiner Forschungsergebnisse vor Journalisten in Tokio.
Die Forscher haben das Gen in menschliche Nierenzellen transferiert, damit auch diese das Bärtierchenprotein produzieren. Als Kunieda diese Zellkulturen dann extremer Röntgenstrahlung aussetzte, zeigten sie 40 Prozent weniger Schäden als unbehandelte menschliche Zellen. „Da dieses Gen die Strahlentoleranz in menschlichen Zellkulturen extrem verbessert hat, hoffe ich, dass wir es irgendwann schaffen werden, die Strahlentoleranz größerer Lebewesen zu verbessern“, sagte Kunieda bei der Vorstellung seiner Forschungsergebnisse vor Journalisten in Tokio.
Doch bis die ersten strahlenresistenten Menschen auf Weltraumreise gehen, wird wohl noch viel Zeit vergehen. Es sei um einiges schwieriger, die Strahlenresistenz eines ganzen Tieres zu erhöhen als die eines kleinen Zellhaufens, dämpften die Forscher allzu hohe Erwartungen.
Anwendung in der Medizin möglich
 Mögliche Anwendungen der neuen Erkenntnisse gibt es dagegen viele. Denkbar sei beispielsweise die Herstellung von strahlenresistenten Pflanzen für die Nahrungsversorgung bei langen Aufenthalten im All, so Kunieda.
Mögliche Anwendungen der neuen Erkenntnisse gibt es dagegen viele. Denkbar sei beispielsweise die Herstellung von strahlenresistenten Pflanzen für die Nahrungsversorgung bei langen Aufenthalten im All, so Kunieda.
„Diese Erkenntnis wird uns hoffentlich in ferner Zukunft helfen, Menschen besser für die Raumfahrt und die Arbeit in strahlenden Umgebungen auszurüsten“, sagte er. Darüber hinaus könne sich die Erkenntnis auch in der Medizin als hilfreich erweisen, etwa bei der Strahlentherapie zur Krebsbehandlung, so der Forschungsleiter weiter. Möglicherweise könnten Therapien gefunden werden, die die Zerstörung von gesundem Gewebe um den Tumor herum verhindern.
Von unserer Korrespondentin Susanne Steffen

 De Maart
De Maart







Sie müssen angemeldet sein um kommentieren zu können